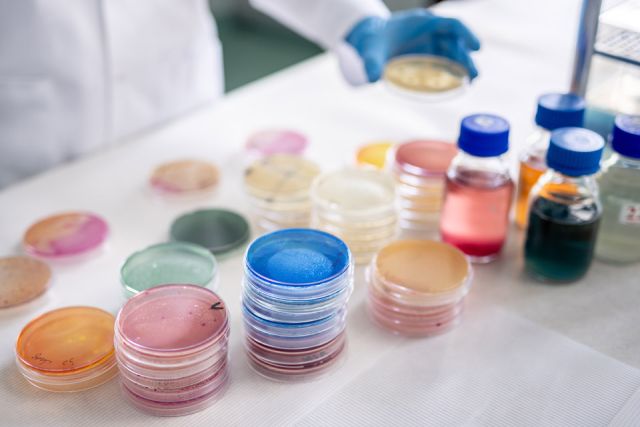
Dr Damian Rolbiecki, photo: Łukasz Bera

Principal Investigator
:
Dr Damian Rolbiecki
University of Warmia and Mazury in Olsztyn
Panel: NZ9
Funding scheme
: PRELUDIUM 20
announced on
15 March 2021
 Dr Damian Rolbiecki, photo: Łukasz Bera
Modern medicine faces one of the greatest challenges of our time — the increasing resistance of bacteria to antibiotics. The World Health Organization (WHO) recognises this as one of the ten most serious threats to public health. Antibiotics that only recently saved the lives of millions of people are increasingly failing because bacteria have learned how to protect themselves. This problem is particularly evident in hospitals. In the hospital environment, where antibiotics are used widely and patients often require long-term treatment, strong selective pressure arises — bacteria learn to survive, retain and accumulate resistance traits. Such microorganisms can spread not only between patients and staff, causing hard-to-control hospital infections, but also exit the hospital with wastewater. Billions of bacteria, including dangerous strains such as Escherichia coli and Klebsiella pneumoniae equipped with antibiotic resistance genes, enter the sewage system along with water and waste from medical wards. These microorganisms then move on to the urban sewer network, wastewater treatment plants and the natural environment, where they may interact with typical environmental bacteria. Such contact promotes the exchange of genetic material and further dissemination of resistance genes. Additionally, this “escape route” gives dangerous strains the opportunity to adapt to natural environments and colonise new ecological niches. These processes can lead to the spread of resistance mechanisms in aquatic and soil ecosystems and increase the risk of reappearance of resistant bacteria in humans and animals — in the form of infections that are difficult to treat.
Dr Damian Rolbiecki, photo: Łukasz Bera
Modern medicine faces one of the greatest challenges of our time — the increasing resistance of bacteria to antibiotics. The World Health Organization (WHO) recognises this as one of the ten most serious threats to public health. Antibiotics that only recently saved the lives of millions of people are increasingly failing because bacteria have learned how to protect themselves. This problem is particularly evident in hospitals. In the hospital environment, where antibiotics are used widely and patients often require long-term treatment, strong selective pressure arises — bacteria learn to survive, retain and accumulate resistance traits. Such microorganisms can spread not only between patients and staff, causing hard-to-control hospital infections, but also exit the hospital with wastewater. Billions of bacteria, including dangerous strains such as Escherichia coli and Klebsiella pneumoniae equipped with antibiotic resistance genes, enter the sewage system along with water and waste from medical wards. These microorganisms then move on to the urban sewer network, wastewater treatment plants and the natural environment, where they may interact with typical environmental bacteria. Such contact promotes the exchange of genetic material and further dissemination of resistance genes. Additionally, this “escape route” gives dangerous strains the opportunity to adapt to natural environments and colonise new ecological niches. These processes can lead to the spread of resistance mechanisms in aquatic and soil ecosystems and increase the risk of reappearance of resistant bacteria in humans and animals — in the form of infections that are difficult to treat.
 Dr Damian Rolbiecki, photo: Łukasz Bera
To limit this risk, many hospitals disinfect wastewater before it is discharged into the sewer system, most commonly using chlorine. Chlorine effectively destroys many bacteria and viruses and has been widely used for decades. However, an increasing number of studies suggest that the action of chlorine may also have unexpected side effects. Experiments indicate that although chlorine deactivates some microorganisms, bacteria that survive this stress trigger numerous defence mechanisms, including increased frequency of genetic material exchange, which may favour the transfer of resistance genes.
Dr Damian Rolbiecki, photo: Łukasz Bera
To limit this risk, many hospitals disinfect wastewater before it is discharged into the sewer system, most commonly using chlorine. Chlorine effectively destroys many bacteria and viruses and has been widely used for decades. However, an increasing number of studies suggest that the action of chlorine may also have unexpected side effects. Experiments indicate that although chlorine deactivates some microorganisms, bacteria that survive this stress trigger numerous defence mechanisms, including increased frequency of genetic material exchange, which may favour the transfer of resistance genes.
In this project, I aimed to test whether disinfection applied in a hospital wastewater treatment unit serves as an effective barrier limiting the spread of antibiotic-resistant bacteria from the hospital to the environment. In the research, I adopted a two-pronged approach.
On the one hand, I worked with live bacteria isolated from wastewater, examining their antibiotic resistance and genetic relatedness. On the other hand, I went a step further by analysing the entire microbial community present in the wastewater. To this end, for the first time in this type of research I applied nanopore sequencing — a modern technique that enables reading the full genetic material present in a sample, i.e. the metagenome. With this method, I could see not only which resistance genes are present in wastewater, but also which bacteria carry them and whether there is potential for gene exchange among them.
The results were alarming. Disinfection parameters did not provide full effectiveness — numerous bacteria, including typically “hospital” antibiotic-resistant species, were still present in disinfected wastewater. These were precisely the bacteria that best tolerated the stress induced by chlorine and survived the disinfection process more often than sensitive strains. Metagenomic analysis confirmed these observations: after chlorination, I more frequently identified associations between bacteria and resistance genes, as well as new combinations of them. The results indicate that the disinfection process itself may have facilitated gene transfer among microorganisms.
The research showed that wastewater disinfection — although crucial for safety — does not always function as expected. Under non-optimal parameters, this process may not only fail to eliminate the presence of resistant bacteria in the wastewater but may even promote the spread of their resistance mechanisms. These findings highlight the importance of precise control of disinfection parameters and effectiveness, as well as the search for alternative methods that more effectively reduce the risk of transmission of antibiotic-resistant bacteria into the environment.
Project title: Metagenome of hospital wastewater – impact of wastewater disinfection on the microbiome and resistome of wastewater
Dr Damian Rolbiecki
Graduate of the University of Warmia and Mazury in Olsztyn. Since 2024, he has worked at the European Regional Centre for Ecohydrology of the Polish Academy of Sciences in Łódź, where he participates in the development of an innovative photonic system for monitoring water resources. He studies antibiotic resistance in bacteria within the One Health framework, analysing the spread of resistant and virulent pathogens in aquatic environments, with particular focus on Klebsiella pneumoniae.